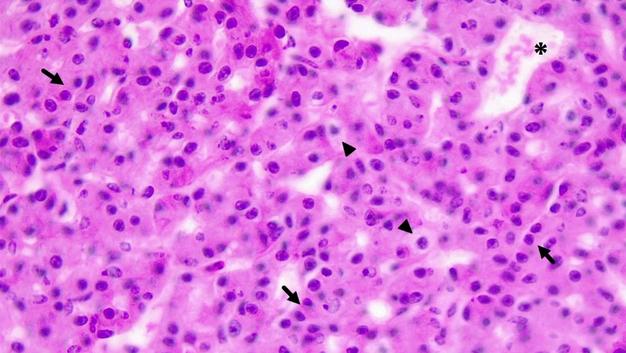
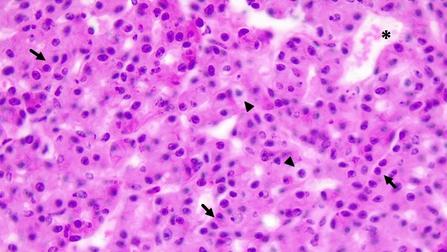

Fuente:ArchivodelaCátedradeHistologíayEmbriología,FCVUNLP RecuadroenB:modificadoapartirdeesquema,cortesíadela Dra EvelyneVila-Porcile D Autores:Larkin,S yAnsorge,O (verref)
B. Parte distal.
1 Vasos sanguíneos.
Línea discontinua: folículo.
Flechas delgadas: células acidófilas.
Recuadro: folículo
Flechas: células folículoestrelladas
A. Imagen panorámica de un sector de la glándula hipófisis.
Pd: parte distal;
Pi: parte intermedia;
Pn: parte nerviosa.
Asterisco (*): Cavidad hipofisaria

Fuente:ArchivodelaCátedradeHistologíayEmbriología,FCVUNLP RecuadroenB:modificadoapartirdeesquema,cortesíadela Dra EvelyneVila-Porcile D Autores:Larkin,S yAnsorge,O (verref)

Fuente:ArchivodelaCátedradeHistologíayEmbriología,FCVUNLP RecuadroenB:modificadoapartirdeesquema cortesíadela Dra EvelyneVila-Porcile D Autores:Larkin,S yAnsorge,O (verref)
C: Parte distal.
Flechas delgadas: células acidófilas.
Flecha gruesa: célula basófila
Círculo: células no secretoras
Fuente:ArchivodelaCátedradeHistologíay Embriología,FCV-UNLP.C.Autores:Larkin,S.y Ansorge,O.(verref.).

A. Izquierda: Neurohipófisis.
Asteriscos: parte intermedia
C. Neurohipófisis.
Círculos: núcleos de pituicitos. Puntas de flecha: vasos sanguíneos
Flecha: cuerpo de Herring.
Fuente:ArchivodelaCátedradeHistologíay Embriología,FCV-UNLP C Autores:Larkin,S y Ansorge,O.(verref.).

B. Neurohipófisis.
Círculos: núcleos de pituicitos. Puntas de flecha: vasos sanguíneos.

Fuente:ArchivodelaCátedradeHistologíay Embriología,FCV-UNLP C Autores:Larkin,S y Ansorge,O.(verref.).
Rev investig vet Perúvol33 no4Limajul/ago 2022 Epub 31-Ago-2022

Pinealocitos. Presencia de patrón en cordones (flechas negras) y en rosetas (flechas rojas) en la glándula pineal de una alpaca

Presencia de neuroglias (flechas negras) en zona perivascular y proyecciones citoplasmáticas (flechas rojas) acidófilas en la glándula pineal de una alpaca
B.
1: coloide en la luz folicular.
2: vaso sanguíneo.
Punta de flecha: células foliculares.
Flecha: célula parafolicular

Células parafoliculares

Puntasdeflecha: células oxífilas.
Flecha: células principales.
Asterisco: (*) vaso sanguíneo.
Constituida por 4 capas
Zona Intermedia entre la glomerular y la fasciculada

https://wwwinstagramcom/histo logica?igsh=MWdhNmRubG5rcjRrcw==



Fuente:ArchivodelaCátedrade HistologíayEmbriología,FCV-UNLP.
B: Corteza adrenal.
cap: cápsula
1: zona glomerular
2: zona fasciculada
3: zona reticular
A: Imagen panorámica
Líneadiscontinua: límite entre corteza y médula cap: cápsula

Fuente:ArchivodelaCátedrade HistologíayEmbriología,FCV-UNLP.

Fuente:ArchivodelaCátedrade HistologíayEmbriología,FCV-UNLP.
D: Zona fasciculada
Flechas: Espongiocitos
C: Zona glomerular o arcuata.

Fuente:ArchivodelaCátedrade HistologíayEmbriología,FCV-UNLP.

Fuente:ArchivodelaCátedrade HistologíayEmbriología,FCV-UNLP.
E: zona reticular. puntasdeflecha:vasos sanguíneos.
F: Médula. Asterisco:(*) vena medular central.

Fuente:ArchivodelaCátedrade HistologíayEmbriología,FCV-UNLP.

_completo.pdf
http://www.scielo.org.pe/scielo.php?script=sci arttext&pid=S160991172022000400003